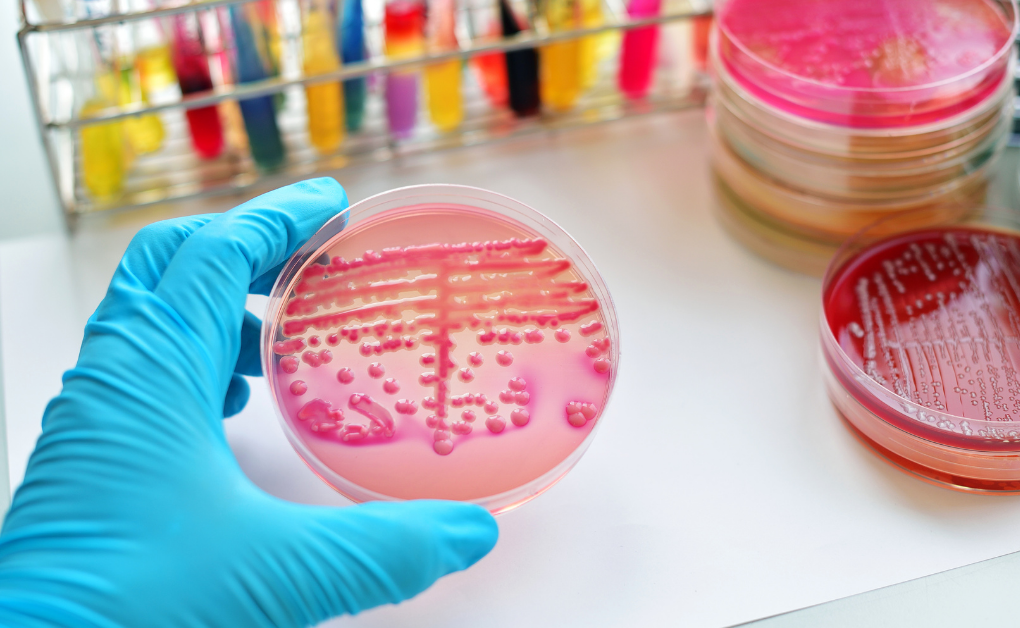
Pseudomonas Problem in Pharma Industry

Water is an important raw material in the pharma industry. Any contamination of water can severely impact the quality of the final product. This is why it is crucial that the water used in the pharma industry is pure and free from contamination and germs.
However, water may be exposed to critical contaminants from time to time, one of them being Pseudomonas aeruginosa – a gram-negative microorganism that creates havoc in various industries. P. aeruginosa is a commonly occurring bacterium in soil, water, and healthcare environments. The bacterium has many virulence factors, such as lipopolysaccharides (LPS), adhesins, lectins, flagella, biofilm formation and antimicrobial resistance.
Water contamination from Pseudomonas aeruginosa is a serious concern in pharmaceutical manufacturing. This occurs primarily in water-based systems such as cooling towers, water storage tanks, and water purification systems. Cross-contamination by Pseudomonas aeruginosa may also occur in water injection tanks, pipelines, and water used for industrial processes.
In this article, we will discuss the problem of water pollution from Pseudomonas aeruginosa in the pharma industry. We will also explain why UV water treatment is among the best solutions to address this problem.
Pseudomonas growth in water causes severe problems for the pharma industry-
When water utilized for pharmaceutical manufacturing is contaminated with Pseudomonas, it can result in alterations in the chemical characteristics of the medicines. The bacteria can put human health at risk, especially immuno-compromised patients. In instances where Pseudomonas contamination has been confirmed by microbiological tests, it can lead to a series of consequential events including product recalls, regulatory action, and hindrance to the manufacturer’s reputation.

Pseudomonas contamination can be prevented by implementing stringent water quality measures, regularly disinfecting pharma water systems, and monitoring them frequently. There are various approaches to treat water for maintaining the standard of the end products. These include reverse osmosis, ultraviolet water purification and ozonation.
UV system for water treatment plant is an effective and non-chemical method. It successfully eliminates the concern of accumulation of chemical residues that could contaminate pharmaceutical products. When it comes to UV sterilization for pharmaceuticals for controlling P. aeruginosa, it is recommended that the UV water systems are regularly monitored and maintained to ensure a longer shelf life. UVC water treatment is often used in combination with ozonation to enhance the treatment efficiency. The water undergoes treatment with ozone first, and then it is subjected to UVC light.
Ozonation involves introducing ozone in water, where it reacts with organic and inorganic particles and works as an oxidant. It also eliminates various microbial contaminants, including P. aeruginosa. Ozone possesses the ability to break through biofilm structures, thus destroying the existing ones and preventing biofilm formations. For effectively reducing Pseudomonas contamination in water, the required ozone residual concentration is around 0.1 to 0.5 mg/l. The accurate dose can be best determined by conducting a pilot test.
Once the water has been exposed to ozonation, it is treated with UV-C light having a wavelength of 253.7 nm. The required UV-C dose to kill Pseudomonas aeruginosa in water can differ, based on factors such as initial bacterial growth density, water quality, and specifications of the UV system. However, studies indicate that the approximate dose of UV-C needed for a 99.9% Pseudomonas control in water is 10-20 mJ/cm2. This dose may change with the strain of P. aeruginosa, any modifications of the bacteria as per external parameters, or variations in its sensitivity to UV radiation.
UV water treatment system works by damaging microbial genome, inhibiting their growth and reproduction. The process by which UV-C water treatment disrupts the genetic material of microorganisms is known as photodimerization, characterized by covalent bonds between adjacent nucleic acid bases ninth genome, creating pyrimidine dimers. These dimers then bring about distortion in the genetic structure, which prevents the normal replication and transcription processes. In this way, UV light makes microbes incapable of reproducing and forming biofilms. Another feature of UV radiation in water purification is that it aids in decomposing any residual ozone in water into oxygen, thus safeguarding the final product from any chemical contamination.
This combined technology of ozonation and UV disinfection keeps the pipelines clean and intact, destroys biofilms, and prevents P. aeruginosa contamination.
One of the best ways to address the problem of Pseudomonas contamination is to integrate water treatment systems with efficient UV disinfection technologies. It can be combined with ozonation for enhanced efficacy towards Pseudomonas control. Both these processes effectively reduce microbial contamination and associated risks, thus ensuring that the water utilized for pharmaceutical products is of the highest standards.

Alfaa UV (Ace Hygiene Products Pvt. Ltd.) is an ISO 9001 certified company. With two decades of experience, Alfaa UV is the undisputed leader and exporter of UV purification systems for Water and Air treatment. Based in Mumbai, Alfaa UV has its own fully integrated manufacturing facility in Talegaon, Maharashtra and a pan India presence with sales and service offices across the country. Alfaa UV systems are also exported to over 15 countries around the world. Behind the company’s products are some of the most experienced and knowledgeable professionals in the industry from engineering, chemistry and microbiological backgrounds. Alfaa’s R&D team creates many of today’s successful UV technology innovations.
We develop various UV systems for water treatment, including technologies specific to remove Pseudomonas contamination. Key features of our UV disinfection equipment for water treatment are:
Ultraviolet UV water purification systems for drinking water disinfection...Read More
Ultraviolet UV water purification systems for process Water Disinfection...Read More
Ultraviolet UV water purification systems for waster water tertiary treatment...Read More
Ultraviolet UV water purification systems for Swimming pool and spas...Read More

Ultraviolet UV water purification systems for the Reduction of Total Oxidizable Carbons ( TOC )...Read More

Ultraviolet UV water purification systems for Ozone destruction...Read More

Ultravoilet UV air purification systems for...Read More
Imagine waking up one day to discover that the tap has run d... Read More
With countless water purification options available, it̵... Read More
WHY AIR-CONDITIONED CLASSROOMS SHOULD USE UVGI TECHNOLOGY TO... Read More
They say that imitation is sincerest form of flattery... Read More
Are you tired of constantly being affected by seasonal aller... Read More
Introduction Indoor air quality plays a crucial role in main... Read More
Hello dear readers! In today’s post, we will be sheddi... Read More
Please leave a message for more details and we will get back to you soon.
Comments ( 2 )
You’ve simplified a subject that has always confused me, thank you!
I have read some excellent stuff here Definitely value bookmarking for revisiting I wonder how much effort you put to make the sort of excellent informative website